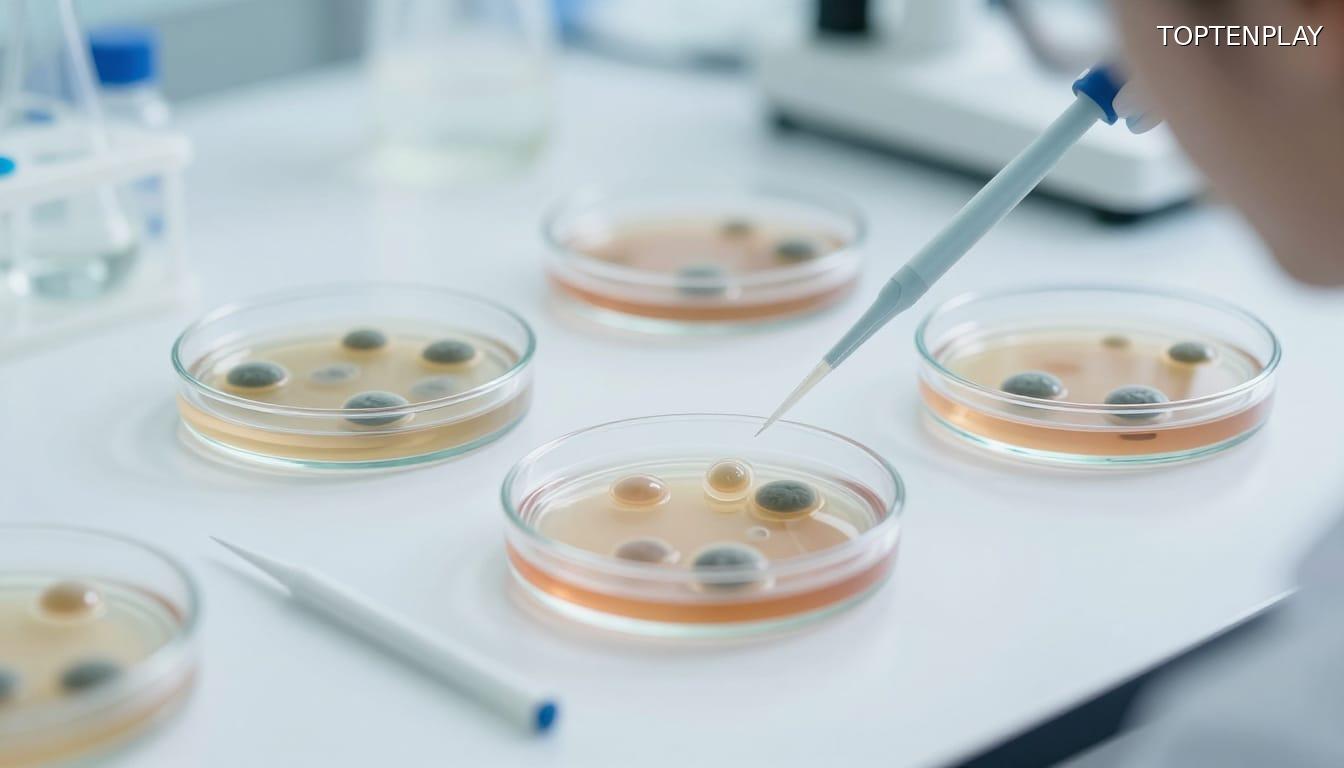
Image d'illustration © TopTenPlay

Méningite Bactérienne : Une Urgence Vitale Qui Tue En Moins De 24 Heures
Une fièvre qui grimpe, un mal de tête tenace, une fatigue écrasante après une soirée entre amis : pour la plupart, les symptômes d’un simple virus saisonnier. Pourtant, derrière ces signes banals peut se cacher une menace foudroyante. En France, une méningite bactérienne peut tuer un adulte en bonne santé en moins de 24 heures. Le cerveau n’a presque aucun délai pour se défendre quand la bactérie envahit les méninges.
L’Organisation Mondiale de la Santé livre des chiffres glaçants : environ une personne sur six atteinte de méningite bactérienne décède, et une sur cinq garde des séquelles neurologiques importantes. En France, la létalité atteint 20 %, avec autant de survivants marqués à vie. Ces formes graves restent rares, mais leur brutalité ne laisse aucune marge d’erreur.
Les populations les plus vulnérables ? Les nourrissons, dont le système immunitaire reste immature. Les adolescents et jeunes adultes de 15 à 24 ans, surtout ceux vivant en internat ou en colocation, où la promiscuité favorise la transmission. Les personnes âgées, dont les défenses s’affaiblissent. Pour eux, reconnaître les premiers signaux devient une question de survie.
Face à cette infection qui progresse à une vitesse vertigineuse, comprendre comment la bactérie se propage devient essentiel.
Comprendre L’Ennemi : Le Méningocoque, Une Bactérie Présente Chez 10% De La Population
La bactérie responsable, Neisseria meningitidis, se loge dans le nez ou la gorge d’environ 10 % de la population sans provoquer le moindre symptôme. Ces porteurs sains constituent un réservoir invisible, propageant le méningocoque par de simples gouttelettes respiratoires lors de conversations, de toux ou de rires partagés. Foyers étudiants, casernes, soirées en milieu fermé : autant d’environnements où la bactérie circule en silence.
Quand elle franchit la barrière du nez vers le sang, puis vers les méninges, l’inflammation devient fulgurante. Contrairement aux méningites virales, souvent bénignes et spontanément résolutives, la forme bactérienne engage le pronostic vital en quelques heures. La souche B reste majoritaire en France, mais les méningocoques W et Y progressent dangereusement, avec un taux de létalité pouvant atteindre 20 %.
Les chiffres récents confirment une recrudescence inquiétante : les infections invasives à méningocoque ont bondi de 72 % en 2023 par rapport à 2022. Des clusters ont été signalés en Angleterre, et le 19 mars 2026, une femme est décédée d’une forme foudroyante à Cherbourg. Cette progression silencieuse exige une vigilance accrue sur les symptômes révélateurs de l’infection.

La Triade Mortelle : 3 Symptômes Qui Exigent Un Appel Immédiat Aux Urgences
Face à cette progression alarmante, identifier les signes d’alerte devient vital. Le premier symptôme consiste en des céphalées d’une intensité inhabituelle, très différentes des migraines classiques, résistant aux antalgiques usuels. Elles s’accompagnent d’une fièvre élevée et d’une photophobie marquée. Chez l’adulte, la nuque se raidit : pencher la tête en avant provoque une douleur vive, signature du syndrome méningé.
Les vomissements en jet constituent le deuxième signal d’alarme. Ils surviennent brutalement, sans lien avec un repas ni diarrhée associée, ce qui les distingue nettement d’une gastro-entérite banale. La personne bascule rapidement vers la confusion, la somnolence, peine à répondre aux questions. Chez le nourrisson, le tableau diffère : bébé mou qui se réveille difficilement, fontanelle bombée, refus total de s’alimenter.
Le troisième signe, le plus spectaculaire, reste le purpura fulminans. Présent dans environ 30 % des cas, il se manifeste par de petites taches rouges ou violacées sur la peau. Le test du verre permet de le reconnaître : appliquer un verre transparent sur les taches. Si elles ne pâlissent pas sous la pression, il faut agir immédiatement. Ce purpura signe une septicémie gravissime pouvant conduire à l’amputation de membres. Devant cette triade, chaque minute compte pour sauver une vie.

Réflexes De Survie : Protocole D’Urgence Et Prévention Vaccinale Obligatoire
Face à cette triade de symptômes, la réaction doit être immédiate. Composer le 15 (SAMU) ou le 112, décrire précisément les signes observés et suivre les consignes sans attendre que la situation se dégrade. Les équipes médicales engagent le traitement antibiotique dès la suspicion, sans attendre la confirmation biologique. Cette anticipation change radicalement le pronostic : chaque heure perdue accroît le risque de décès ou de séquelles irréversibles.
Le protocole hospitalier enchaîne rapidement ponction lombaire pour identifier la bactérie, perfusion d’antibiotiques à forte dose et surveillance en réanimation si nécessaire. L’entourage proche reçoit un traitement préventif pour éviter toute propagation. Cette prise en charge ultra-rapide explique pourquoi l’appel aux urgences ne doit jamais être retardé, même en pleine nuit ou pour un simple doute.
La prévention vaccinale constitue désormais la première ligne de défense. Depuis le 1er janvier 2025, les vaccins contre le méningocoque B et les sérogroupes A, C, W, Y sont obligatoires chez le nourrisson en France. La recommandation s’étend aux 15-24 ans, particulièrement exposés en collectivité, ainsi qu’aux personnes immunodéprimées. Cette stratégie réduit drastiquement le risque d’infection invasive, même si elle ne l’élimine pas totalement. Connaître les symptômes d’alerte reste donc indispensable, vaccination ou non, pour réagir à temps et éviter l’irréparable.



